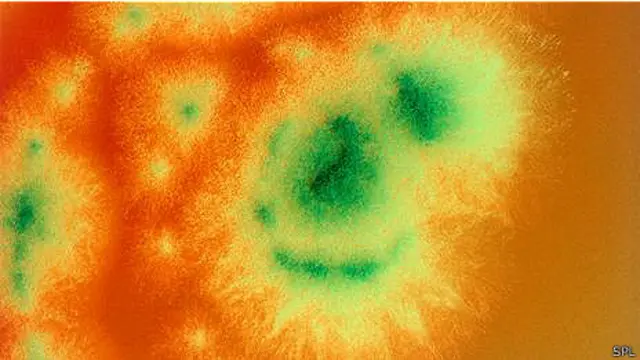
Penicillium roqueforti – грибок, живущий во французских пещерах

Странная и удивительная жизнь внутри сыра

Автор фото, Thinkstock
- Автор, Вероник Гринвуд
- Место работы, BBC Future
Живые обитатели сыра - от бактерий с пальцев ног до грибковой жижи – придают ему неповторимый вкус. Корреспондент <link type="page"><caption> BBC Future</caption><url href="http://www.bbc.com/future" platform="highweb"/></link> заглянула в микромир, о котором мы редко думаем за обедом.
Сыр некогда представлял собой в первую очередь способ продлить срок хранения молока, а в наши дни стал лакомством гурманов. Экстремальные виды сыра привлекают любителей пищевых приключений – от английского стилтона с фрагментами золота до касу марцу с Сардинии, кишащего живыми личинками. Отдельные энтузиасты даже делали сыр с использованием бактерий из подмышек и с пальцев ног.
<italic><link type="page"><caption> (Похожие статьи из раздела "Журнал")</caption><url href="http://www.bbc.co.uk/russian/topics/vert_fut" platform="highweb"/></link> </italic>
Впрочем, не обязательно быть эстетом, чтобы любить сыры. Каждый из них представляет собой жилище, построенное бактериями и грибками, и у каждого сорта есть свой, скажем так, архитектурный стиль – в зависимости от предпочтений его создателей.
Процесс сыроварения начинается со смешивания молока с лактобациллами или стрептококками, вырабатывающими молочную кислоту. Потом добавляется фермент, который расщепляет молочные белки. В результате белки оседают комками, притягивая за собой шарики жира. Сыровары отделяют полученную массу от оставшейся жидкости, прессуют ее в формы и готовят сыр к созреванию.
В ходе созревания другие микробы придают сырам их неповторимый характер. Взять, к примеру, рокфор – мягкий французский сыр, усыпанный сине-зелеными отверстиями. Строит его плесневая культура под названием Penicillium roqueforti, она естественным образом встречается в природе в пещерах Франции, где выдерживают настоящий рокфор. Однако сыровары в других уголках мира могут искусственно добавить ее в сыр для получения аналогичного эффекта.
Автор фото, SPL
P. roqueforti – штука капризная. Эта плесень любит воздух, но погибает при слишком большой концентрации кислорода. Поэтому сыровары протыкают головки сыра металлическими штырями, оставляя небольшие отверстия, в которых грибок мог бы успешно развиваться. Освоившись на новом месте жительства, плесень начинает вырабатывать ферменты, расщепляющие жир на жирные кислоты (которые придают слегка мыльный вкус) и метилкетоны, отвечающие за специфический аромат. Плесень также вырабатывает токсины, которые в чистом виде вызывают у мышей повреждения сердца, легких, печени и почек. Однако в сырной среде они распадаются на не столь опасные соединения.
Мягкие сыры с белой оболочкой из плесени, вроде камамбера – это настоящие общежития грибков. Главный обитатель здесь - Penicillium camemberti. Этот грибок поселяется на поверхности и производит ферменты, устраивающие цепную реакцию, которая распространяется к самому центру сырной головки. Потребляя соль молочной кислоты, они делают головку более кислой на поверхности, чем в сердцевине – что в свою очередь заставляет ионы фосфата кальция, изначально прочно встроенные в структуру сыра, подняться на поверхность.

Автор фото, Getty
Смена кислотности и движение ионов приводят к разжижению внутренности сыра. На его поверхности тем временем продолжается расщепление белков – в результате образуется аммиак, который растворяется в сыре и придает камамберу характерный запах.
Эти химические качели сопровождаются рядом других реакций, подробнее описанных в этой работе на тему созревания сыра. Вот одна из лучших цитат оттуда: "Сам по себе запах метионала, похожий на запах вареного картофеля, не очень приятен. Однако в сочетании с другими летучими веществами он составляет одну из нот букета таких сыров, как камамбер и чеддер".
В рассольных сырах, к примеру, эпуасе или лимбургере, которые на разных стадиях процесса созревания промывают соленой водой, живут бактерии Brevibacterium linens. Они придают сыру очень специфический запах несвежих носков, производя бутановую и изовалериановую кислоты. У запаха потных ног и правда аналогичный источник: та же бактерия живет и на коже стоп.
Вонь лимбургера привлекает самок кровососущих комаров: авторы этого открытия получили в 2006 году Шнобелевскую премию. "Неплохая идея: простая ловушка для комаров в спальне на основе синтезированного запаха человека", - начинается посвященная этому открытию статья в серьезном научном журнале Lancet, предлагающая снаряжать комариные ловушки лимбургером. Сыры, созданные B. linens, действительно сильно воняют, но вызывают восторг у посвященных гурманов. (Вот краткое введение в рассольные сыры в статье сайта Serious Eats.)

Автор фото, Getty
В производстве английского сыра чеддер применяются менее радикальные процессы, дающие, соответственно, более умеренные результаты. Эти сыры как правило вызревают только при помощи изначально введенных лактобацилл, без дополнительной плесени. Однако в них все равно присутствует множество разных молекул, придающих им характерный аромат.
Понюхав чеддер, можно заметить, что его букет на самом деле очень сложен. Он пикантный, но при этом сладковатый, соленый и нежный.
На самом деле, описать аромат сыра не проще, чем букет вина – у профессионалов для этого есть специальный набор терминов. В ходе исследования в 2001 году специалисты продегустировали 240 разновидностей чеддера и придумали 27 терминов для описания ноток их ароматов, в том числе: кошачий (для описания запаха кошачьей мочи), коровий (запах хлева), ореховый, бульонный и фруктовый.

Автор фото, Thinkstock
Проводившиеся веками практические эксперименты дали нам сегодняшнее многообразие сыров. Ученые по-прежнему разбираются, какую роль в сыроварении играют отдельные микроорганизмы – зачастую для этого приходится начинать с молекулярного состава сыра и образцов бактерий и выяснять, как вторые влияют на первый.
Но чем больше мы узнаем о биологических процессах, тем больше интереса представляет сыр. В следующий раз, взрезая построенный бактериями дом – круг камамбера или клин чеддера – воздайте должное их нелегкому архитектурно-кулинарному труду.
<italic>Прочитать<link type="page"><caption> оригинал этой статьи</caption><url href="http://www.bbc.com/future/story/20141114-the-strange-world-inside-cheese" platform="highweb"/></link> на английском языке можно на сайте <link type="page"><caption> BBC Future</caption><url href="http://www.bbc.com/future" platform="highweb"/></link>.</italic>










